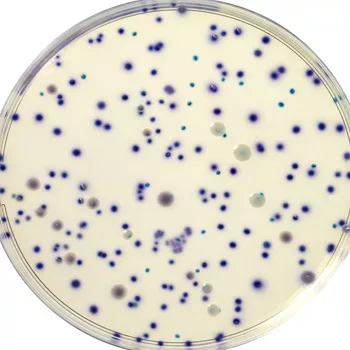

Rapid E.coli Test Speeds Lab Work for Dietary Supplement Maker
Getting food sample test results as quickly as possible is always at the top of the wish list for the majority of food industry laboratories. Speed-to-result translates into a positive bottom-line impact for food manufacturers, allowing shorter product hold-and-release time that gets the product on the retail shelf and in front of the consumer that much faster.
This is one reason why rapid microbiological tests are so popular, says one microbiology testing laboratory supervisor from a multinational nutritional dietary supplement manufacturing company. “Even though our products have a longer shelf life than fresh-cut produce or similar retail items, as a consumer product manufacturer we are always under pressure to get product out as quickly as possible. A rapid test allows you to fill orders more quickly and requires less warehousing time. Any time you can release product into the marketplace fast , the company management is happier.”
In addition, she adds, rapid test results can provide a good economic impact at the front end of manufacturing. “The faster results we get from using rapid test methods means that incoming raw materials are in quarantine for less time, which means you can shorten your time to production and maintain your production schedules.”
But obtaining fast results isn’t the only “most wanted” item on the microbiology lab supervisor’s list. The test has to be accurate and easy to read. Any savings in time or labor provided by the speed of the testing process and subsequent results is negated if those results are unreadable, unclear, or indicate false positives that require additional hold time while further testing is conducted.
One of the ways that her laboratory—which performs a variety of tests to ensure the microbiological integrity of a broad range of botanical, synthetic and natural nutritional supplement ingredients and finished product—achieves this level of bottom-line results is by using Bio-Rad Laboratories Inc.’s RAPID’E. coli 2™ as its method of choice for qualitative generic E. coli testing. While this AOAC Research Institute Performance TestedSM selective chromogenic medium can also be used for direct enumeration of E. coli and other coliform bacteria in food products, the lab supervisor explains that her company focuses on testing for total number of organisms and screening for specific organisms based on compendial method requirements and standards for dietary supplements.
“We use generic E. coli as an indicator organism method because it is specifically listed in industry standards and/or in the monographs of applicable compendial methods, such as the U.S. Pharmaecopia,” she notes. “So we test to comply with those standards, as well as to meet our own company’s test specifications.”
Faster, Broad-Based Test Helps Address All Matrices
The challenge, she adds, was to find a rapid method equivalent to or better than the traditional agar-based compendial method that could be used for a wide range of sample matrices. The company’s microbiology laboratory analyzes 50 to 100 samples each day on average, ranging from raw botanical ingredients to finished products in powder, tablet, two-piece capsule and gel-cap forms. “One of the things we like about RAPID’E. coli 2 is that even with the many sample matrices with which we work each day—some are powders, some are pigmented, and the textures or viscosities of the samples range fromchunky, to liquid, to oily—this single test can address all those different factors and still deliver the fast, clear results we need to get product out.”
Clear, accurate results that are easier to read than traditional testing methods is the other major benefit for this dietary supplement maker’s laboratory. “The compendial method we used is an selective and differential agar method that that helps distinguish Gram negative bacteria, but it is not as easy to differentiate when reading the plate and we’d have more results that are questionables. And, of course, when we have questionable results we have to hold the lots longer to investigate whether the positives are real or not,” says the lab supervisor.
“For us, this is the big advantage of using the RAPID’E. coli 2 medium as a qualitative test, because we are looking at whether the sample is positive or negative, and we can see that quite clearly with the specific colors of the colonies that appear when E. coli is present,” she notes. “Using a chromogenic agar has made our job in the lab easier because it is easier to differentiate the organisms. If we get a questionable, we isolate, Gram stain and ID it just as we would do with other methods, but since using the RAPID’E. coli 2 test we appear to be doing less ID work because it allows us to eliminate questionable sample results and establish samples as not having objectionable organisms present in the earlier stages of the testing process.”
Due to the nature of its products, the lab handles a lot of samples that are botanical in origin which often have inherent bioburden, such as Enterobacteriae and other bacteria closely related to E. coli. With the highly specific Bio-Rad test—coliforms form blue to green colonies, whereas specifically E. coli form violet to pink colonies—background organisms that might cause a questionable reaction on another agar are no longer a problem for lab technicians.
“For all of these reasons,” she adds,” the RAPID’E. coli 2 test method is not only faster and more accurate than many of the traditional compendial methods against which we evaluated it side by side,” notes the microbiology lab supervisor, “but it is also more economical. Using this test has definitely resulted in time and labor savings for our lab.”
www.foodscience.bio-rad.com
Looking for quick answers on food safety topics?
Try Ask FSM, our new smart AI search tool.
Ask FSM →








